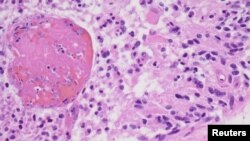
FILE - A high magnification image from a 2012 glioblastoma case is seen as an example in this College of American Pathologists image released from Northfield, Ill., July 20, 2017.

Smrt senatora Johna McCaina je privukla pažnju javnosti na jednu bolest o kojoj se malo priča, a kada se priča, priča se sa strahopoštovanjem: glioblastom.
Glioblastom spada u najagresivnije oblike tumora moždanog tkiva, a nastaje usljed poremećaja stanica mozga od kojih nastaju tzv. „potporne stanice“( glija stanice, astrociti i oligodendrociti). Drugim riječima, mutacije određenih tipova matičnih stanica moždanog tkiva su uzrok ovog oblika tumora. Čini oko 15% svih tumora mozga.
Procjenjuje se da od glioblastoma godišnje oboli 3 od 100.000 ljudi te da je ovaj oblik tumora češći kod muškaraca nego kod žena. Također, glioblastom se češće razvija kod osoba iznad 60 godina starosti. Oko 20% osoba kojima se dijagnosticira preživi godinu dana, a manje od 5% preživi unutar 5 godina nakon postavljanja dijagnoze. Što je pacijent stariji, to je prognoza lošija.
Simptomi glioblastoma su nespecifični i dešava se da oboljeli zanemare neke od takvih simptoma, poput glavobolja i mučnine. Nekada su ovi simptomi intenzivni i podsjećaju na moždani udar ili dolazi do povremenih gubitaka svijesti te upravo to bude razlog zašto se ljudi obrate ljekaru. Dijagnoza se postavlja kombinacijom CT-a, MRI skeniranja i biopsije. Još neki od potencijalnih simptoma uključuju napade, promjene u ponašanju i nerazumljiv govor.
Stvarni uzroci gliobastoma su još uvijek nejasni, kao i potencijalni faktori rizika. Neki od faktora su mutacije i nasljedna oboljenja poput neurofibromatoze (još jedan tip tumora nervnog sistema), Li-Fraumeni i Turcot sindroma. Glioblastom se ne povezuje sa upotrebom mobitela, kao ni sa konzumacijom procesuiranog mesa. Terapija radijacijom se smatra za još jedan od rizika.
Nažalost, zbog teške dostupnosti ovih tumora i vrlo ograničenog znanja koje savremena medicina ima o glioblastomima, ova bolest se smatra neizlječivom. Glioblastomi su veoma otporni na konvencionalne terapije, poput kemoterapije, posebno zbog toga što malo lijekova može proći barijeru krv-mozak – fiziološku barijeru koja štiti mozak od prodora toksina i patogena iz krvi. Uvriježeno je mišljenje da kemoterapija nije od pomoći u slučaju glioblastoma, ali su 2004. rađena određena klinička istraživanja efikasnosti kemoterapije temozolomidom u kombinaciji sa radioterapijom.
Sam mozak ima veoma ograničene mehanizme da ukloni stanice tumora. Samo u određenim slučajevima rano otkrivenih glioblastoma koji su u povoljnom položaju radi se hirurška intervencija, ali ni takve intervenciije ne mogu u potpunosti ukloniti tumor. U takvim slučajevima, ostatak tumora se pokušava ukloniti terapijom radijacije. Terapija u težim slučajevima je uglavnom suportivna i palijativna, kako bi se pacijentu olaškao život i smanjila bol.
Genska terapija, imunološki pristup u liječenju tumora te viroterapija su novi potencijalni načini liječenja glioblastoma. Međutim, do dana današnjeg, svi pokušaji genske terapije glioblastoma su propali, najviše zbog toga što se jasno ne znaju genetički uzroci ovog oboljenja.
Terapije koje najviše obećavaju u ranim slučajevima otkrivanja glioblastoma, pogotovo kod osoba mlađih od 60 godina jesu terapije virusima (viroterapije). Naime, određeni virusi koji inficiraju ljude, poput zika virusa, virusa bjesnila i virusa dječije paralize, mogu proći barijeru krv-mozak te naučnici pokušavaju genetičkim inženjeringom stvoriti sojeve ovih virusa koji su manje opasni, ali sposobni da dođu do moždanog tkiva i transportiraju terapiju na mjesto glioblastoma ili potaknu sam organizam na borbu protiv tumora.
Za zika virus je utvrđeno da nije opasan toliko za odrasle, koliko za fetus, jer preko posteljice prolazi u krv nerođene bebe i dospijeva u mozak, gdje izaziva trajna oštećenja matičnih stanica nervnog sistema koja se očituju kao mikrocefalija (smanjen volumen mozga). Međutim, istraživanje tima sa Univerziteta Kalifornija San Diego, iz 2017. godine, objavljeno u časopisu The Journal of Experimental Medicine, pokazalo je kako zika virus ima onkolitičko djelovanje (razara stanice tumora) na stanice glioblastoma. Rezultati ovog rada, kako oni na izdvojenim stanicama glioblastoma u petrijevkama, tako i oni na miševima, bili su obećavajući.
U junu ove godine objavljeni su i rezultati naučnika sa Duke University School of Medicine koji su koristili genetički modificiran virus - himeru virusa dječije paralize i rinovirusa (polio–rhinovirus chimera, PVSRIPO) u kliničkim testovima na ljudima koji boluju od glioblastoma. U radu objavljenom u The New England Journal of Medicine pokazano je da je stopa preživljavanja oboljelih unutar 3 godine povećana u odnosu na pacijente koji nisu primili terapiju modificiranim virusom. Modificirani virus uništava sam stanice tumora, ali i aktivira imuni odgovor samog pacijenta da se bori sa stanicama tumora. Terapija ima nus-pojava, jer je virus polia veoma potentan i izaziva inflamaciju, koja dovodi do oticanja mozga.
Na Univerzitetu Texas A&M u College Station pokušavaju pokušavaju razviti kronokemoterapiju u kojoj bi se smanjila proizvodnja jednog proteina povezanog sa rastom tumora u svrhu liječenja glioblastoma. Kronoterapija uključuje korištenje prirodnih ciklusa odmora i aktivnosti organizma, kako bi se postigao maksimalni učinak.
Iz National Brain Tumor Society je stigla izjava povodom smrti senatora McCaina u kojoj se izražava duboka tuga i poziva na ulaganje napora kako bi se ova bolest istražila i kako bi se pronašle efikasne terapije.